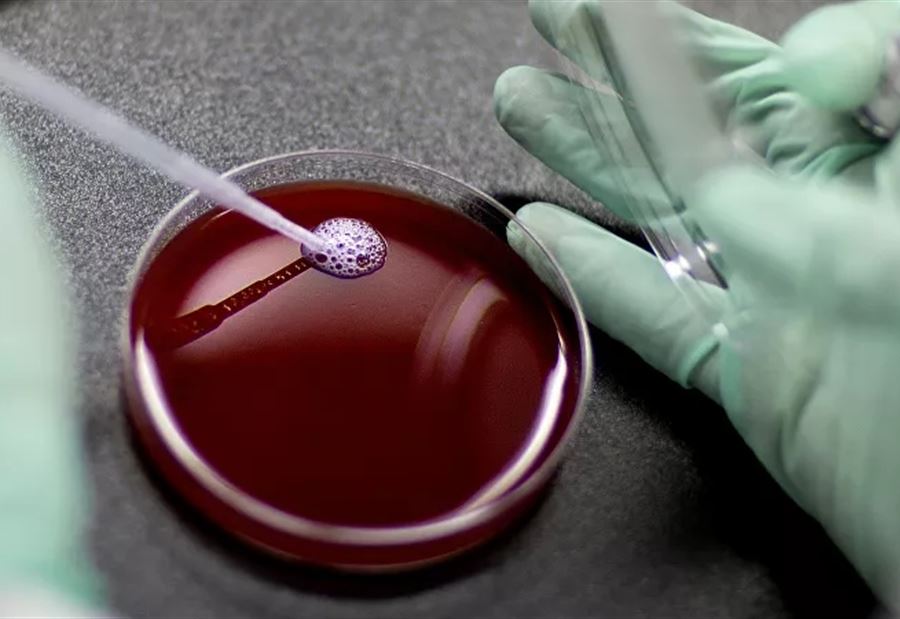

تتكون جلطات الدم عندما تتكاثف أجزاء معينة من الدم، مكونة كتلة شبه صلبة، ناجمة عن إصابة أو يمكن -في بعض الأحيان- أن تحدث داخل الأوعية الدموية بدون إصابة واضحة.
وبمجرد أن تتشكل هذه الجلطات، يمكن أن تنتقل إلى أجزاء أخرى من الجسم، مسببة أضرارا خطرة. فيما يلي نستعرض العوامل والحالات التي يمكن أن تسبب جلطات دموية مزعجة، بالإضافة إلى الحالات الخطيرة المرتبطة بجلطات الدم، بحسب موقع "مايو كلينك" الطبي.
تصلب الشرايين.
النوبة القلبية.
السمنة.
الحَمل.
التدخين.
السكتة الدماغية.
الجراحة.
مرض كوفيد-19.
اضطراب نظم القلب.
الجلوس المُطَوَّل أو الراحة في الفراش.
يشار إلى أن بعض خثرات الدم تتكون داخل الأوردة بدون سبب نافع ولا تذوب مثل هذه الجلطات بصورة طبيعية، وقد تتطلب مثل هذه الجلطات تلقي العناية الطبية لاسيِّما إِذا كانت في الساقين أو في أماكن خطيرة أُخرى في الجسم كالرئتين والدماغ.
تــابــــع كــل الأخــبـــــار.
إشترك بقناتنا على واتساب

Follow: Lebanon Debate News

الـــمــــزيــــــــــد
الـــمــــزيــــــــــد





